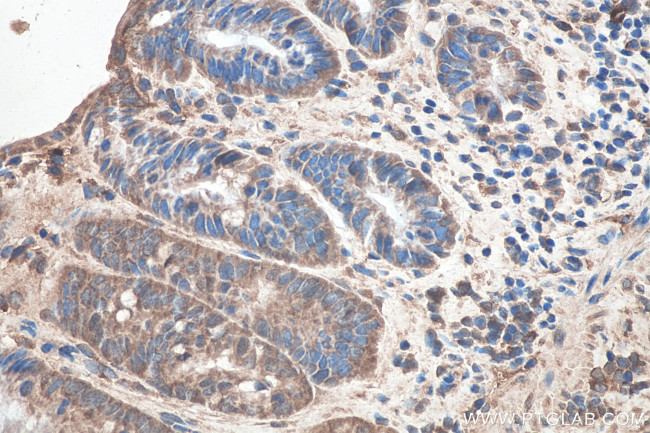
SETDB1 Antibody in Immunohistochemistry (Paraffin) (IHC (P))

Search
Proteintech
SETDB1 Monoclonal Antibody (1H6E5)
{{$productOrderCtrl.translations['antibody.pdp.commerceCard.promotion.promotions']}}
{{$productOrderCtrl.translations['antibody.pdp.commerceCard.promotion.viewpromo']}}
{{$productOrderCtrl.translations['antibody.pdp.commerceCard.promotion.promocode']}}: {{promo.promoCode}} {{promo.promoTitle}} {{promo.promoDescription}}. {{$productOrderCtrl.translations['antibody.pdp.commerceCard.promotion.learnmore']}}
产品信息
66293-1-IG
种属反应
宿主/亚型
分类
类型
克隆号
抗原
偶联物
形式
浓度
规格
纯化类型
保存液
内含物
保存条件
运输条件
产品详细信息
Immunogen sequence: MSSLPGCIG LDAATATVES EEIAELQQAV VEELGISMEE LRHFIDEELE KMDCVQQRKK QLAELETWVI QKESEVAHVD QLFDDASRAV TNCESLVKDF YSKLGLQYRD SSSEDESSRP TEIIEIPDED DDVLSIDSGD AGSRTPKDQK LREAMAALRK SAQDVQKFMD AVNKKSSSQD LHKGTLSQMS GELSKDGDLI VSMRILGKKR TKTWHKGTLI AIQTVGPGKK YKVKFDNKGK SLLSGNHIAY DYHPPADKLY VGSRVVAKYK DGNQVWLYAG IVAETPNVKN KLRFLIFFDD GYASYVTQSE LYPICRPLKK TWEDIEDISC RDFIEEYVTA YPNRPMVLLK S (1-350 aa encoded by BC009362)
靶标信息
This gene encodes a histone methyltransferase. The encoded enzyme catalyzes the reaction of S-adenosyl-L-methionine and histone L-lysine to produce S-adenosyl-L-homocysteine and histone N(6)-methyl-L-lysine. The encoded protein likely functions in transcriptional repression. Alternatively spliced transcript variants have been described.
仅用于科研。不用于诊断过程。未经明确授权不得转售。
篇参考文献 (0)
生物信息学
蛋白别名: ERG-associated protein with a SET domain, ESET; ERG-associated protein with SET domain; ESET; H3-K9-HMTase 4; Histone H3-K9 methyltransferase 4; Histone-lysine N-methyltransferase SETDB1; histone-lysine N-methyltransferase, H3lysine-9 specific 4; KIAA0067; Lysine N-methyltransferase 1E; SET domain bifurcated 1; SET domain ERG-associated histone methyltransferase; tudor domain containing 21; unnamed protein product
基因别名: AU022152; ESET; H3-K9-HMTase4; KG1T; KIAA0067; KMT1E; mKIAA0067; SETDB1; TDRD21
UniProt ID: (Human) Q15047
Entrez Gene ID: (Human) 9869, (Mouse) 84505, (Rat) 689883